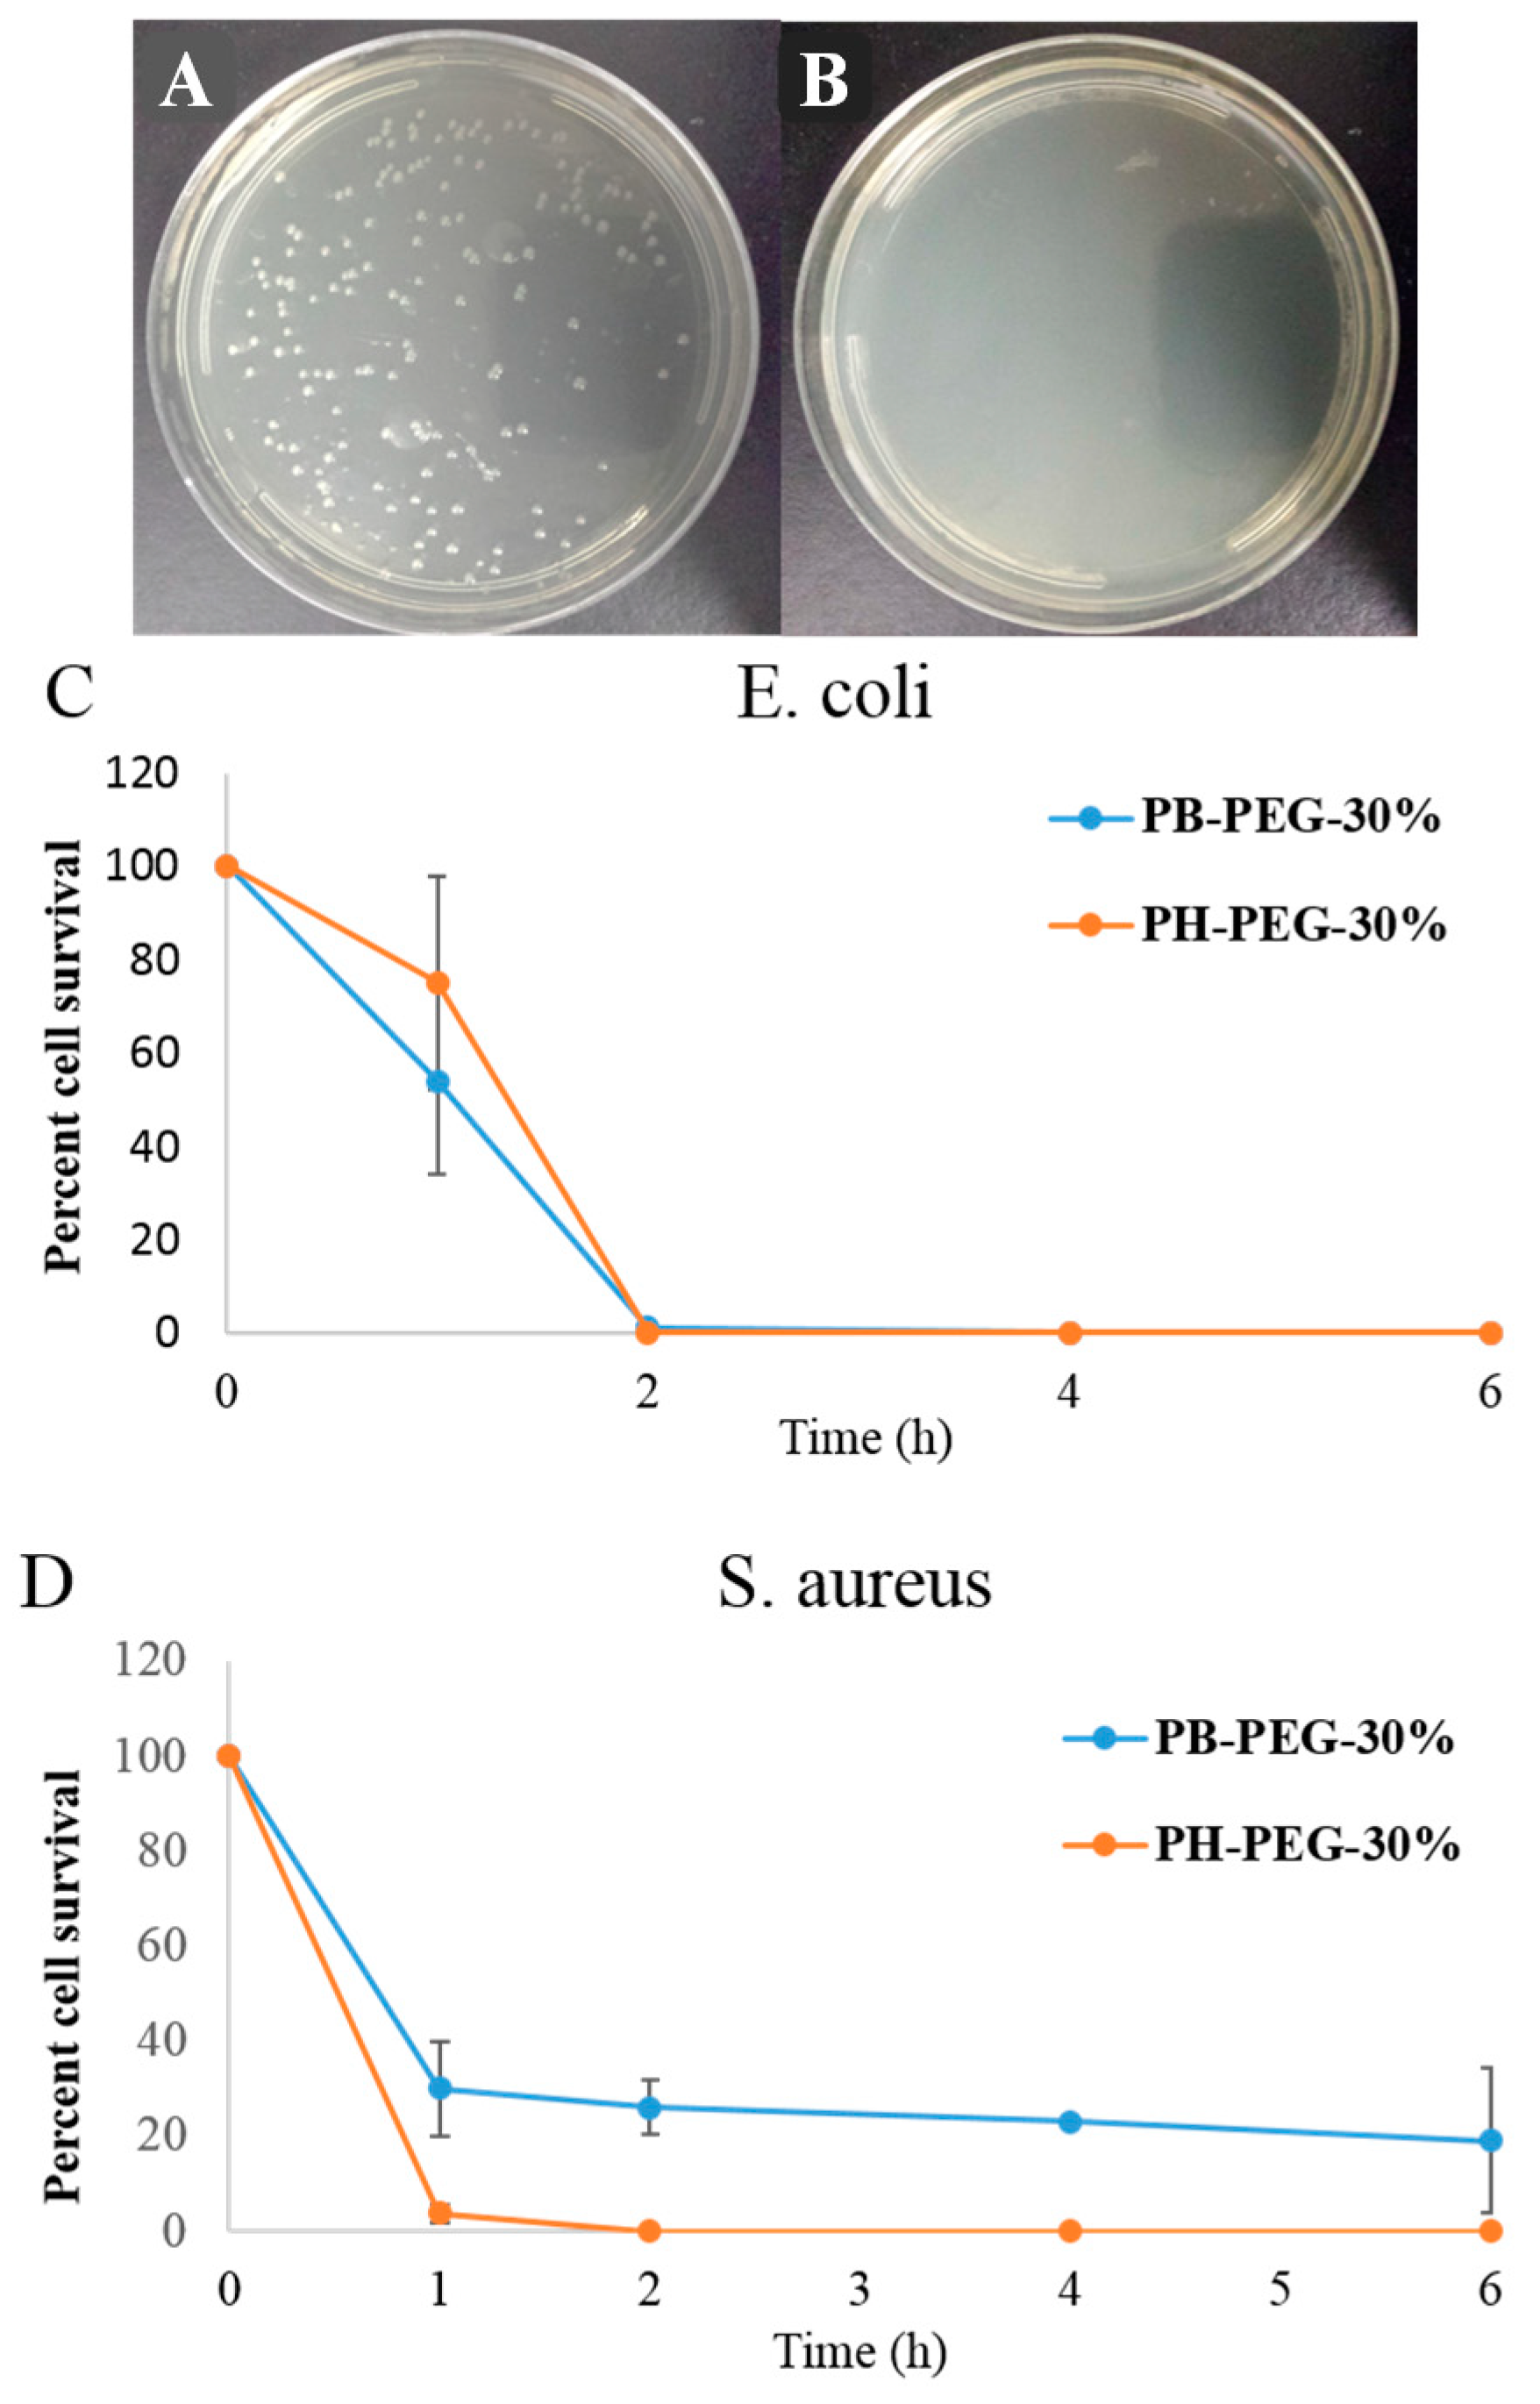
Ijms 16 23867 g003 1024

Effect of Relative Arrangement of Cationic and Lipophilic Moieties on Hemolytic and Antibacterial Activities of PEGylated Polyacrylates
Abstract
:1. Introduction
2. Results and Discussion
2.1. Synthesis of Copolymers

2.2. Antibacterial Activity of Copolymers

| Copolymer | Alkyl Side Group | Mol % PEGMA-300 (Actual) | Mn [g/mol] kDa | MIC E. coli [µg/mL] | MIC S. aureus [µg/mL] | HC50 RBC [µg/mL] | Selectivity HC50/MIC | |
|---|---|---|---|---|---|---|---|---|
| E. coli | S. aureus | |||||||
| PB-PEG-0% | Butyl | 0% | 4.0 | 16 | 62 | <12 | <1 | <1 |
| PB-PEG-10% | Butyl | 17% | 4.2 | 52 | 83 | <12 | <1 | <1 |
| PB-PEG-20% | Butyl | 23% | 3.8 | 42 | 125 | 24 | <1 | <1 |
| PB-PEG-30% | Butyl | 33% | 4.1 | 31 | 250 | 140 | 4.5 | <1 |
| PB-PEG-40% | Butyl | 44% | 4.2 | 62 | 604 | 317 | 5 | <1 |
| PB-PEG-50% | Butyl | 53% | 4.5 | 167 | 1143 | 1000 | 6 | <1 |
| PB-PEG-75% | Butyl | 72% | 4.6 | 2000 | 2000 | 2000 | 1 | 1 |
| PH-PEG-0% | Hexyl | 0% | 3.4 | 62 | 42 | <12 | <1 | <1 |
| PH-PEG-10% | Hexyl | 11% | 3.6 | 16 | 62 | <12 | <1 | <1 |
| PH-PEG-20% | Hexyl | 21% | 3.8 | 21 | 83 | 24 | 1 | <1 |
| PH-PEG-30% | Hexyl | 27% | 3.9 | 21 | 384 | 24 | 1 | <1 |
| PH-PEG-40% | Hexyl | 35% | 4.6 | 42 | 384 | 62 | 1.5 | <1 |
| PH-PEG-50% | Hexyl | 46% | 4.6 | 83 | 1143 | 125 | 1.5 | <1 |
| PH-PEG-75% | Hexyl | 72% | 6.4 | 1190 | 2000 | 1500 | 1.3 | <1 |
| PM6-100 * | Hexyl | 0% | 5.8 | 6.5 | 16 | <1.9 | <1 | <1 |
| PM6-90-PEG300 * | Hexyl | 10% | 5.1 | 7.8 | 31 | 83 | 11 | 2.6 |
| PM6-70-PEG300 * | Hexyl | 33% | 5.2 | 16 | 62 | >1809 | >113 | >29 |
| PM6-50-PEG300 * | Hexyl | 50% | 5.1 | 104 | 250 | >2000 | >19 | >8 |
| PM6-30-PEG300 * | Hexyl | 71% | 5.9 | >1809 | >2000 | >200 | >1 | 1 |
2.3. Hemolytic Activity of Copolymers
2.4. Time Dependent Killing Efficiency of Copolymers
3. Experimental Section
3.1. Materials
3.2. Instrumentation
3.3. N-Boc Protection of Ethanolamine
3.4. Synthesis of 2-((Tert-butoxycarbonyl)amino)ethyl Acrylate Monomer
3.5. Synthesis of Copolymers
3.6. Antibacterial Activity Test
3.7. Hemolytic Activity Test
3.8. Time Dependent Killing Efficiency Test
4. Conclusions
Supplementary Materials
Acknowledgments
Author Contributions
Conflicts of Interest
References
- Jabes, D. The antibiotic R&D pipeline: An update. Curr. Opin. Microbiol. 2011, 14, 564–569. [Google Scholar] [PubMed]
- Boucher, H.W. Challenges in anti-infective development in the era of bad bugs, no drugs: A regulatory perspective using the example of bloodstream infection as an indication. Clin. Infect. Dis. 2010, 50, S4–S9. [Google Scholar] [CrossRef] [PubMed]
- Peleg, A.Y.; Hooper, D.C. Hospital-acquired infections due to gram-negative bacteria. N. Engl. J. Med. 2010, 362, 1804–1813. [Google Scholar] [CrossRef] [PubMed]
- Klevens, R.M.; Edwards, J.R.; Richards, C.J., Jr.; Horan, T.C.; Gaynes, R.P.; Pollock, D.A.; Cardo, D.M. Estimating health care-associated infections and deaths in U.S. hospitals, 2002. Public Health Rep. 2007, 122, 160–166. [Google Scholar] [PubMed]
- Stone, P.W.; Hedblom, E.C.; Murphy, D.M.; Miller, S.B. The economic impact of infection control: Making the business case for increased infection control resources. Am. J. Infect. Control 2005, 33, 542–547. [Google Scholar] [CrossRef] [PubMed]
- Review on Antimicrobial Resistance. Availabel online: http://amr-review.org/ (accessed on 9 September 2015).
- Muñoz-Bonilla, A.; Fernández-García, M. Polymeric materials with antibacterial activity. Prog. Polym. Sci. 2012, 37, 281–339. [Google Scholar] [CrossRef]
- Engler, A.C.; Wiradharma, N.; Ong, Z.Y.; Coady, D.J.; Hedrick, J.L.; Yang, Y. Emerging trends in macromolecular antimicrobials to fight multi-drug-resistant infections. Nano Today 2012, 7, 201–222. [Google Scholar] [CrossRef]
- Zasloff, M. Antimicrobial peptides of multicellular organisms. Nature 2002, 415, 389–395. [Google Scholar] [CrossRef] [PubMed]
- Brogden, K.A. Antimicrobial peptides: Pore formers or metabolic inhibitors in bacteria? Nat. Rev. Microbiol. 2005, 3, 238–250. [Google Scholar] [CrossRef] [PubMed]
- Boman, H.G. Innate immunity and the normal microflora. Immunol. Rev. 2000, 173, 5–16. [Google Scholar] [CrossRef] [PubMed]
- Sovadinova, I.; Palermo, E.F.; Urban, M.; Mpiga, P.; Caputo, G.A.; Kuroda, K. Activity and mechanism of antimicrobial peptide-mimetic amphiphilic polymethacrylate derivatives. Polymers 2011, 3, 1512–1532. [Google Scholar] [CrossRef]
- Oda, Y.; Kanaoka, S.; Sato, T.; Aoshima, S.; Kuroda, K. Block versus random amphiphilic copolymers as antibacterial agents. Biomacromolecules 2011, 12, 3581–3591. [Google Scholar] [CrossRef] [PubMed]
- Lienkamp, K.; Tew, G.N. Synthetic mimics of antimicrobial peptides—A versatile ring-opening metathesis polymerization based platform for the synthesis of selective antibacterial and cell-penetrating polymers. Chem. Eur. J. 2009, 15, 11784–11800. [Google Scholar] [CrossRef] [PubMed]
- Palermo, E.F.; Kuroda, K. Chemical structure of cationic groups in amphiphilic polymethacrylates modulates the antimicrobial and hemolytic activities. Biomacromolecules 2009, 10, 1416–1428. [Google Scholar] [CrossRef] [PubMed]
- Gabriel, G.J.; Maegerlein, J.A.; Nelson, C.F.; Dabkowski, J.M.; Eren, T.; Nusslein, K.; Tew, G.N. Comparison of facially amphiphilic versus segregated monomers in the design of antibacterial copolymers. Chem. Eur. J. 2009, 15, 433–439. [Google Scholar] [CrossRef] [PubMed]
- AL-Badri, Z.M.; Som, A.; Lyon, S.; Nelson, C.F.; Nusslein, K.; Tew, G.N. Investigating the effect of increasing charge density on the hemolytic activity of synthetic antimicrobial polymers. Biomacromolecules 2008, 9, 2805–2810. [Google Scholar] [CrossRef] [PubMed]
- Song, A.; Walker, S.G.; Parker, K.A.; Sampson, N.S. Antibacterial studies of cationic polymers with alternating, random, and uniform backbones. ACS Chem. Biol. 2011, 6, 590–599. [Google Scholar] [CrossRef] [PubMed]
- Zhang, J.; Markiewicz, M.J.; Mowery, B.P.; Weisblum, B.; Stahl, S.S.; Gellman, S.H. C-terminal functionalization of nylon-3 polymers: Effects of C-terminal groups on antibacterial and hemolytic activities. Biomacromolecules 2012, 13, 323–331. [Google Scholar] [CrossRef] [PubMed]
- Punia, A.; He, E.; Lee, K.; Banerjee, P.; Yang, N.-L. Cationic amphiphilic non-hemolytic polyacrylates with superior antibacterial activity. Chem. Commun. 2014, 50, 7071–7074. [Google Scholar] [CrossRef] [PubMed]
- Punia, A.; Mancuso, A.; Banerjee, P.; Yang, N.-L. Nonhemolytic and antibacterial acrylic copolymers with hexamethyleneamine and poly(ethylene glycol) side chains. ACS Macro Lett. 2015, 4, 426–430. [Google Scholar] [CrossRef]
- Palermo, E.F.; Vemparala, S.; Kuroda, K. Cationic spacer arm design strategy for control of antimicrobial activity and conformation of amphiphilic methacrylate random copolymers. Biomacromolecules 2012, 13, 1632–1641. [Google Scholar] [CrossRef] [PubMed]
- Kuroda, K.; DeGrado, W.F. Amphiphilic polymethacrylate derivatives as antimicrobial agents. J. Am. Chem. Soc. 2005, 127, 4128–4129. [Google Scholar] [CrossRef] [PubMed]
- Sellenet, P.H.; Allison, B.; Applegate, B.M.; Youngblood, J.P. Synergistic activity of hydrophilic modification in antibiotic polymers. Biomacromolecules 2007, 8, 19–23. [Google Scholar] [CrossRef] [PubMed]
- Lienkamp, K.; Kumar, K.; Som, A.; Nüsslein, K.; Tew, G.N. “Doubly selective” antimicrobial polymers: How do they differentiate between bacteria? Chem. Eur. J. 2009, 15, 11710–11714. [Google Scholar] [CrossRef] [PubMed]
- Ng, V.W.L.; Tan, J.P.K.; Leong, J.; Voo, Z.X.; Hedrick, J.L.; Yang, Y.Y. Antimicrobial polycarbonates: Investigating the impact of nitrogen-containing heterocycles as quaternizing agents. Macromolecules 2014, 47, 1285–1291. [Google Scholar] [CrossRef]
- Palermo, E.F.; Sovadinova, I.; Kuroda, K. Structural determinants of antimicrobial activity and biocompatibility in membrane-disrupting methacrylamide random copolymers. Biomacromolecules 2009, 10, 3098–3107. [Google Scholar] [CrossRef] [PubMed]
- Kuroda, K.; Caputo, G.A. Antimicrobial polymers as synthetic mimics of host-defense peptides. WIREs Nanomed. Nanobiotechnol. 2012, 5, 49–66. [Google Scholar] [CrossRef] [PubMed]
- Allison, B.C.; Applegate, B.M.; Youngblood, J.P. Hemocompatibility of hydrophilic antimicrobial copolymers of alkylated 4-vinylpyridine. Biomacromolecules 2007, 8, 2995–2999. [Google Scholar] [CrossRef] [PubMed]
- Kameneva, M.V.; Repko, B.M.; Krasik, E.F.; Perricelli, B.C.; Borovetz, H.S. Polyethylene glycol additives reduce hemolysis in red blood cell suspensions exposed to mechanical stress. ASAIO J. 2003, 49, 537–542. [Google Scholar] [CrossRef] [PubMed]
- Sambhy, V.; Peterson, B.R.; Sen, A. Antibacterial and hemolytic activities of pyridinium polymers as a function of the spatial relationship between the positive charge and the pendant alkyl tail. Angew. Chem. 2008, 120, 1270–1274. [Google Scholar] [CrossRef]
© 2015 by the authors; licensee MDPI, Basel, Switzerland. This article is an open access article distributed under the terms and conditions of the Creative Commons Attribution license (http://creativecommons.org/licenses/by/4.0/).
Share and Cite
Punia, A.; Lee, K.; He, E.; Mukherjee, S.; Mancuso, A.; Banerjee, P.; Yang, N.-L. Effect of Relative Arrangement of Cationic and Lipophilic Moieties on Hemolytic and Antibacterial Activities of PEGylated Polyacrylates. Int. J. Mol. Sci. 2015, 16, 23867-23880. https://doi.org/10.3390/ijms161023867
Punia A, Lee K, He E, Mukherjee S, Mancuso A, Banerjee P, Yang N-L. Effect of Relative Arrangement of Cationic and Lipophilic Moieties on Hemolytic and Antibacterial Activities of PEGylated Polyacrylates. International Journal of Molecular Sciences. 2015; 16(10):23867-23880. https://doi.org/10.3390/ijms161023867
Chicago/Turabian StylePunia, Ashish, Kevin Lee, Edward He, Sumit Mukherjee, Andrew Mancuso, Probal Banerjee, and Nan-Loh Yang. 2015. "Effect of Relative Arrangement of Cationic and Lipophilic Moieties on Hemolytic and Antibacterial Activities of PEGylated Polyacrylates" International Journal of Molecular Sciences 16, no. 10: 23867-23880. https://doi.org/10.3390/ijms161023867
APA StylePunia, A., Lee, K., He, E., Mukherjee, S., Mancuso, A., Banerjee, P., & Yang, N.-L. (2015). Effect of Relative Arrangement of Cationic and Lipophilic Moieties on Hemolytic and Antibacterial Activities of PEGylated Polyacrylates. International Journal of Molecular Sciences, 16(10), 23867-23880. https://doi.org/10.3390/ijms161023867

